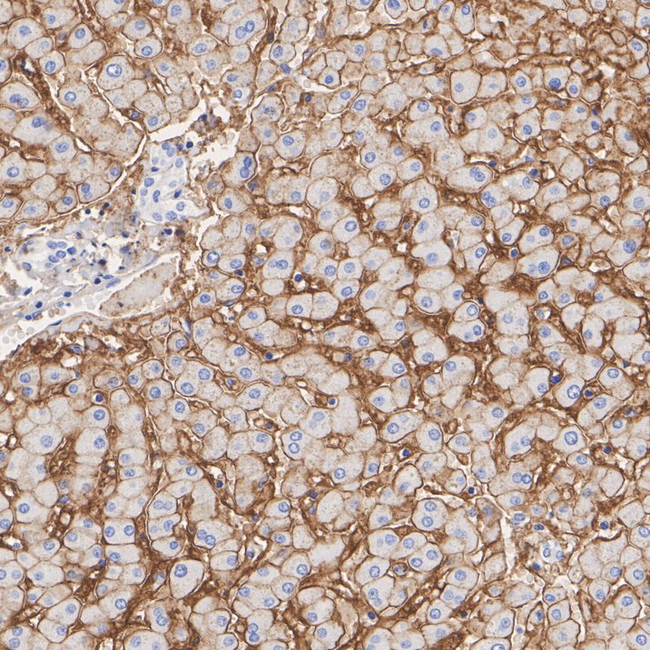
ENPP1 Antibody in Immunohistochemistry (Paraffin) (IHC (P))

Search
Invitrogen
ENPP1 Recombinant Rabbit Monoclonal Antibody (PSH12-11)
{{$productOrderCtrl.translations['antibody.pdp.commerceCard.promotion.promotions']}}
{{$productOrderCtrl.translations['antibody.pdp.commerceCard.promotion.viewpromo']}}
{{$productOrderCtrl.translations['antibody.pdp.commerceCard.promotion.promocode']}}: {{promo.promoCode}} {{promo.promoTitle}} {{promo.promoDescription}}. {{$productOrderCtrl.translations['antibody.pdp.commerceCard.promotion.learnmore']}}
图: 1 / 2
ENPP1 Antibody (MA569989) in IHC (P)


Please note: We are reviewing Western blot images included in the antibody testing data in our catalog, including those provided by third parties. Unless expressly labeled or annotated as “raw-unedited”, Western blot images included in the antibody testing data in our catalog may have been edited, optimized or otherwise adjusted for presentation.
产品信息
MA569989
种属反应
宿主/亚型
Expression System
分类
类型
克隆号
抗原
偶联物
形式
浓度
规格
纯化类型
保存液
内含物
保存条件
运输条件
产品详细信息
Positive control: HepG2 cell lysate, MDA-MB-231 cell lysate, Huh7 cell lysate, human liver tissue.
Subcellular location: Cell membrane, Basolateral cell membrane, Secreted.
靶标信息
This gene is a member of the ecto-nucleotide pyrophosphatase/phosphodiesterase (ENPP) family. The encoded protein is a type II transmembrane glycoprotein comprising two identical disulfide-bonded subunits. This protein has broad specificity and cleaves a variety of substrates, including phosphodiester bonds of nucleotides and nucleotide sugars and pyrophosphate bonds of nucleotides and nucleotide sugars. This protein may function to hydrolyze nucleoside 5' triphosphates to their corresponding monophosphates and may also hydrolyze diadenosine polyphosphates. Mutations in this gene have been associated with 'idiopathic' infantile arterial calcification, ossification of the posterior longitudinal ligament of the spine (OPLL), and insulin resistance.
仅用于科研。不用于诊断过程。未经明确授权不得转售。
篇参考文献 (0)
生物信息学
蛋白别名: alkaline phosphodiesterase 1; Alkaline phosphodiesterase I; E-NPP 1; Ectonucleotide pyrophosphatase/phosphodiesterase family member 1; HGNC:3356; Ly-41 antigen; Membrane component chromosome 6 surface marker 1; membrane component, chromosome 6, surface marker 1; NPPase; Nucleotide diphosphatase; Nucleotide pyrophosphatase; OTTHUMP00000043194; Phosphodiesterase I/nucleotide pyrophosphatase 1; plasma-cell membrane glycoprotein 1; Plasma-cell membrane glycoprotein PC-1; unnamed protein product
基因别名: ARHR2; COLED; ENPP1; M6S1; NPP1; NPPS; PC-1; PC1; PCA1; PDNP1
Entrez Gene ID: (Human) 5167